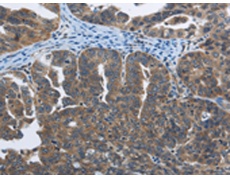
一抗

|
Background: |
Synaptotagmins are a large gene family of synaptic vesicle type III integral membrane proteins that function as regulators of both exocytosis and endocytosis and are involved in neurotransmitter secretion from small secretory vesicles. Calcium binds to Synaptotagmin I which triggers neurotransmitter release at the synapse. Synaptotagmin II is phosphorylated by WNK1 in a process that regulates calcium-dependent interactions. Synaptotagmin III is involved in calcium-dependent exocytosis of secretory vesicles in endocrine cells and neurons. Synaptotagmin IV is expressed in neuronal tissues, and has the highest mRNA levels in the hippocampus. The proximity of the Synaptotagmin IV gene to markers of several psychiatric disorders suggest an involvement of synaptotagmin IV in human disease. Synaptotagmin V is a dense-core vesicle-specific protein that regulates a specific type of calcium-regulated secretion. Synaptotagmin VI interacts with adaptor protein-2 in a calcium-independent manner. Synaptotagmin VII is widely expressed in non-neuronal tissues. |
|
Applications: |
ELISA, IHC |
|
Name of antibody: |
SYT3 |
|
Immunogen: |
Fusion protein of human SYT3 |
|
Full name: |
synaptotagmin III |
|
Synonyms: |
SytIII |
|
SwissProt: |
Q9BQG1 |
|
ELISA Recommended dilution: |
1000-2000 |
|
IHC positive control: |
Human ovarian cancer and human cervical cancer |
|
IHC Recommend dilution: |
50-100 |

 購物車
購物車 幫助
幫助
 021-54845833/15800441009
021-54845833/15800441009